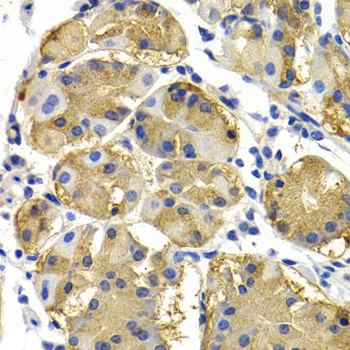

For quotations, please use our online quotation form, and you may also contact us by
service@kendallscientific.com
+1-888.733.6849 (Toll-free)
+1-617.299.7367 (Int’l))
+1-888.733.6849
Our customer service representatives are available 24 hours, Monday through Friday to assist you.| Reactivity | Human Mouse Rat |
| Tested applications | WB IHC |
| Recommended Dilution | WB 1:500 - 1:2000 IHC 1:50 - 1:100 |
| Calculated MW | 47kDa |
| Observed MW | Refer to Figures |
| Immunogen | Recombinant protein of human PTEN |
| Storage Buffer | Store at -20℃. Avoid freeze / thaw cycles. Buffer: PBS with 0.02% sodium azide, 50% glycerol, pH7.3. |
| Concentration | ab |
| Synonym | BZS; DEC; GLM2; MHAM; TEP1; MMAC1; PTEN1; 10q23del; |

Western blot analysis of extracts of HeLa cell lines, using PTEN antibody.

Immunohistochemistry of paraffin-embedded rat heart using PTEN antibody at dilution of 1:200 (40x lens).

Immunohistochemistry of paraffin-embedded rat brain using PTEN antibody at dilution of 1:200 (40x lens).

Immunohistochemistry of paraffin-embedded mouse brain using PTEN antibody at dilution of 1:200 (40x lens).
Immunohistochemistry of paraffin-embedded human normal stomach using PTEN antibody at dilution of 1:200 (40x lens).

Immunohistochemistry of paraffin-embedded human prostate using PTEN antibody at dilution of 1:200 (40x lens).

Immunohistochemistry of paraffin-embedded human gastric using PTEN antibody at dilution of 1:200 (40x lens).

Immunohistochemistry of paraffin-embedded rat heart using PTEN antibody at dilution of 1:100 (40x lens).

Immunohistochemistry of paraffin-embedded human stomach using PTEN antibody at dilution of 1:100 (40x lens).

Immunohistochemistry of paraffin-embedded mouse brain using PTEN antibody at dilution of 1:100 (40x lens).
PTEN (phosphatase and tensin homologue deleted on chromosome ten), also referred to as MMAC (mutated in multiple advanced cancers) phosphatase, is a tumor suppressor implicated in a wide variety of human cancers (1). PTEN encodes a 403 amino acid polypeptide originally described as a dual-specificity protein phosphatase (2). The main substrates of PTEN are inositol phospholipids generated by the activation of the phosphoinositide 3-kinase (PI3K) (3). PTEN is a major negative regulator of the PI3K/Akt signaling pathway (1,4,5). PTEN possesses a carboxy-terminal, noncatalytic regulatory domain with three phosphorylation sites (Ser380, Thr382, and Thr383) that regulate PTEN stability and may affect its biological activity (6,7). PTEN regulates p53 protein levels and activity (8) and is involved in G protein-coupled signaling during chemotaxis (9,10).
N/A